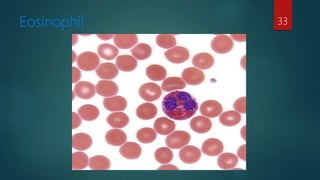
Eosinophil 33
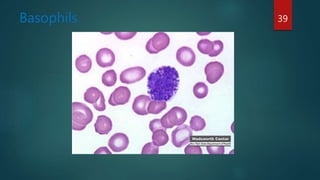
Basophils 39

The document provides an overview of blood, detailing its composition, functions, and the different types of blood cells including red blood cells (RBCs), white blood cells (WBCs), and platelets. It explains the role of blood in transportation, regulation, and protection, as well as specific details about blood cell types and their functions in immunity and clotting. It also describes the biochemical properties of blood plasma and the synthesis of various plasma proteins.






















![Neutrophils
[Polymorphonuclear leukocytes]
Constitute 60 – 70%
12 – 15 µm in diameter in blood smear
Nuclei having two to five lobes
Cytoplasm contains abundant specific granules and azurophilic granules
Short lived with a half life of 6 – 7hrs in blood and a life span of 1 – 4 days
in connective tissue(terminal cell)
23](https://image.slidesharecdn.com/bloodanditscomponents-180605120532/85/Blood-23-320.jpg)
![Neutrophils
[Polymorphonuclear Leukocytes]
Specific granules:
1)Azurophilic(primary): cathepsin, elastase, aryl sulphatase, acid phosphatase
2)Specific (secondary): alkaline phosphatase, lysozyme, collagenase,
lactoferrin, NADPH oxidase
3) Tertiary : gelatinase, cethepsins, glycoprotein that are inserted into
plasmalemma
24](https://image.slidesharecdn.com/bloodanditscomponents-180605120532/85/Blood-24-320.jpg)
![Neutrophils
[Polymorphonuclear Leukocytes]
1. Specific granules: contains varies enzymes and pharmacological agents that aid the
neutrophil in performing its antimicrobial functions. In EM granules appear oblong
2. Azurophilic granules: as already indicated, are lysosomes, containing acid hydrolysis,
myeloperoxidase, antibacterial agent lysozyme, bacterial permeability increasing protein,
cethepsin G, Elastase, Nonspecific collagenase
3. Tertiary granules: contain gelatinase and cethepsins as well as glycoprotein that are inserted
into plasmalemma
25](https://image.slidesharecdn.com/bloodanditscomponents-180605120532/85/Blood-25-320.jpg)
![Neutrophils
[Polymorphonuclear Leukocytes]
26](https://image.slidesharecdn.com/bloodanditscomponents-180605120532/85/Blood-26-320.jpg)
![Neutrophils
[Polymorphonuclear Leukocytes]
27](https://image.slidesharecdn.com/bloodanditscomponents-180605120532/85/Blood-27-320.jpg)
![Neutrophils
[Polymorphonuclear Leukocytes]
Functions :
Considered as defence against invasion of micro organisms
Active phagocytes of small particles and are termed microphages
28](https://image.slidesharecdn.com/bloodanditscomponents-180605120532/85/Blood-28-320.jpg)



![Eosinophils
Eosinophils are responsible for detoxification, disintegration and removal of foreign
proteins.
The lethal substances present in the granules of eosinophils and released at the time of
exposure to parasites or foreign proteins are:
Internum :
1. Major basic protein (MBP) [50%]:arginin,histaminase
2. Eosinophil cationic protein (ECP)
3. Eosinophil-derived neurotoxin
Externum :
Chemotactic factor receptor
32](https://image.slidesharecdn.com/bloodanditscomponents-180605120532/85/Blood-32-320.jpg)